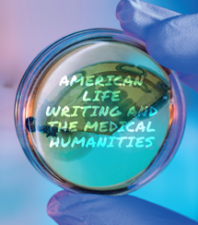
american life writing and the medical humanities : writing contagion

Clinical Data Quality Checks for CDISC Compliance using SAS is the first book focused on identifying and correcting data quality and CDISC compliance issues with real-world innovative SAS programming techniques such as Proc SQL, metadata and macro programming. Learn to master Proc SQL’s subqueries and summary functions for multi-tasking process. Drawing on his more than 25 years’ experience in the pharmaceutical industry, the author provides a unique approach that empowers SAS programmers to take control of data quality and CDISC compliance.
This book helps you create a system of SDTM and ADaM checks that can be tracked for continuous improvement. How often have you encountered issues such as missing required variables, duplicate records, invalid derived variables and invalid sequence of two dates? With the SAS programming techniques introduced in this book, you can start to monitor these and more complex data and CDISC compliance issues. With increased standardization in SDTM and ADaM specifications and data values, codelist dictionaries can be created for better organization, planning and maintenance. This book includes a SAS program to create excel files containing unique values from all SDTM and ADaM variables as columns. In addition, another SAS program compares SDTM and ADaM codelist dictionaries with codelists from define.xml specifications. Having tools to automate this process greatly saves time from doing it manually.
Features
SDTMs and ADaMs Vitals
SDTMs and ADaMs Data
CDISC Specifications Compliance
CDISC Data Compliance
Protocol Compliance

Clinical Data Quality Checks for CDISC Compliance Using SAS
American Life Writing and the Medical Humanities : Writing Contagion
American Life Writing and the Medical Humanities : Writing Contagion
 Abbreviated MRI of the Breast (A Practical Guide) 1st Edition
Abbreviated MRI of the Breast (A Practical Guide) 1st Edition
Clinical Data Quality Checks for CDISC Compliance Using SAS
Original price was: $135.00.$4.99Current price is: $4.99.
-96%




